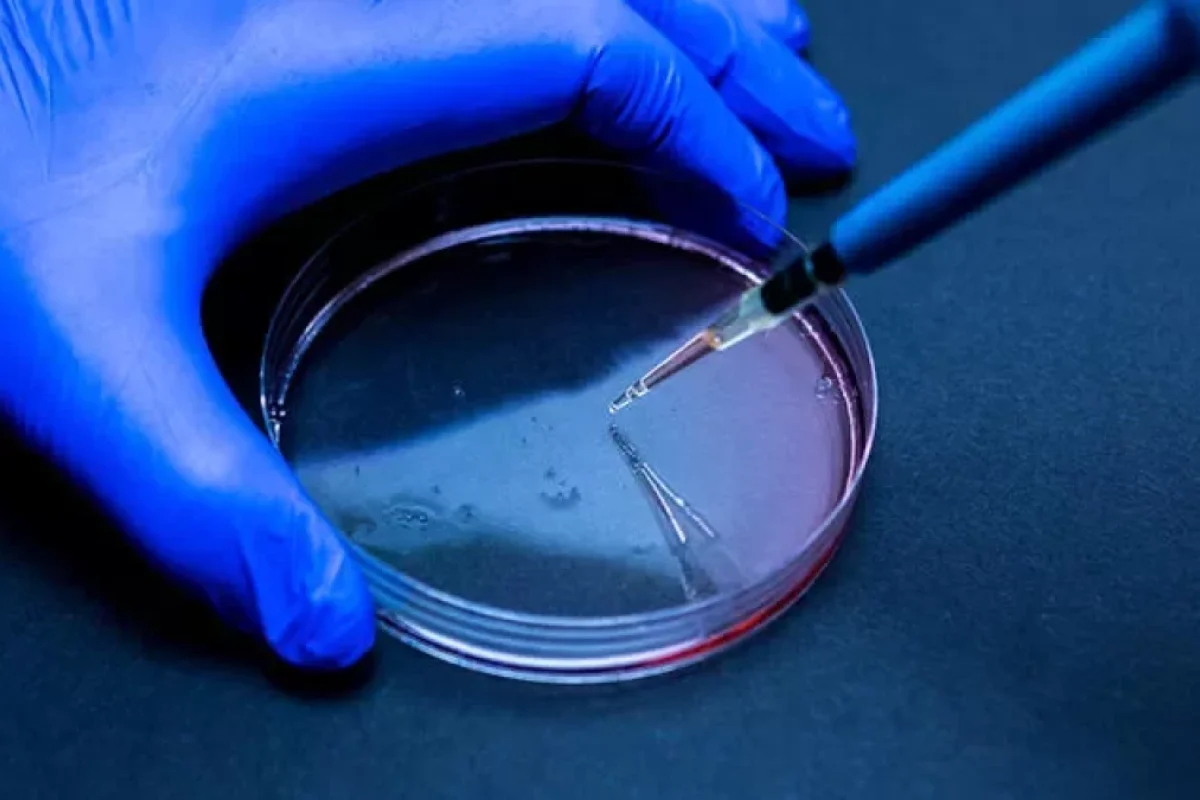
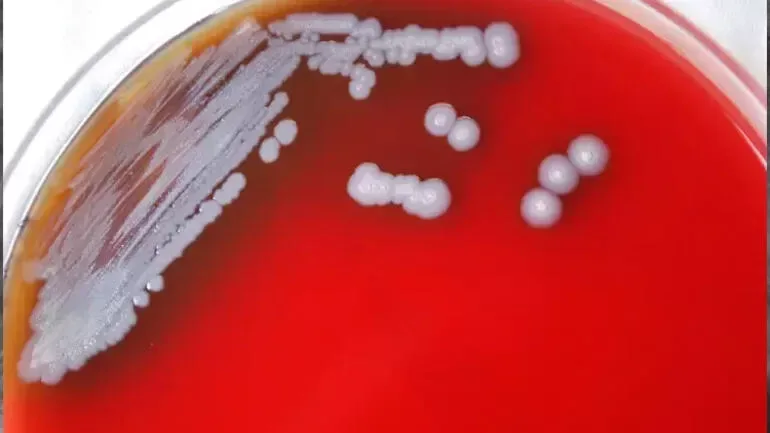
Yeni ölümcül bakteriya aşkarlandı

Yeni ölümcül bakteriya aşkarlandı
Dünya
Dünya
ABŞ-də yeni ölümcül bakteriya aşkarlanıb.
News24.az xarici KİV-ə istinadən xəbər verir ki, “Burkholderia pseudomallei” adlı bakteriya “Melioidosis” xəstəliyinə səbəb olur. Bu xəstəliyin də ciddi nəticələrinin olduğu ortaya çıxıb. Xəstəlik gəmirici, iribuynuzlu və xırdabuynuzlu heyvanlarda rast gəlinir, yoluxucudur.
Qızdırma, oynaq və baş ağrıları kimi simptomlara malikdir. Şəkər, ağciyər və böyrək xəstəlikləri olan şəxslərin yoluxması qorxuludur.
Vüsalə Babaşova

News24.az xarici KİV-ə istinadən xəbər verir ki, “Burkholderia pseudomallei” adlı bakteriya “Melioidosis” xəstəliyinə səbəb olur. Bu xəstəliyin də ciddi nəticələrinin olduğu ortaya çıxıb. Xəstəlik gəmirici, iribuynuzlu və xırdabuynuzlu heyvanlarda rast gəlinir, yoluxucudur.
Qızdırma, oynaq və baş ağrıları kimi simptomlara malikdir. Şəkər, ağciyər və böyrək xəstəlikləri olan şəxslərin yoluxması qorxuludur.
Vüsalə Babaşova